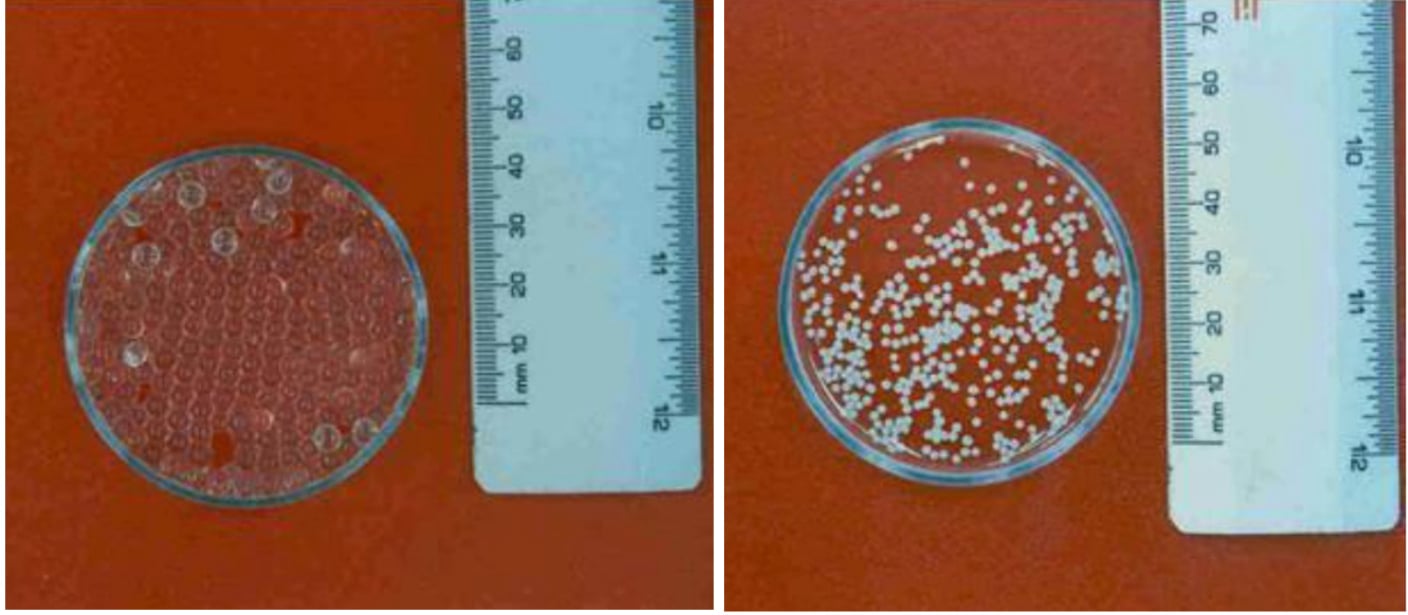

HAKKIMIZDA
Araştırma çalışmalarınız için profesyonel hizmetler
Şirketimiz, gıda mühendisliğinden inşaat mühendisliğine, biyomühendislikten fizik ve kimya mühendisliklerine kadar pek çok mühendislik dalı ile ilgili interdisipliner faaliyetler gerçekleştirmektedir. Özellikle, yeni ve özgün kompozit malzemelerin tasarımı, Ar-Ge ve inovasyon temelli çalışmaları, 33 yıllık akademik deneyim ile buluşturulup geliştirilmektedir.